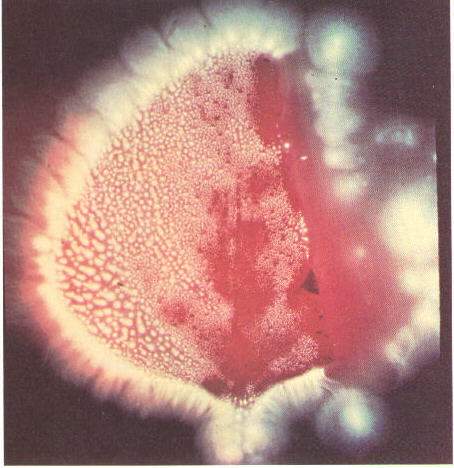
April_18_1999_2.jpg (34817 bytes)

Go back to the Bible and the Book of Mormon this is a new study,totally from the Bible, supporting the divinity of the Book of Mormon.
1 the scriptures are full of words like "light
and truth", used in the same sentence. This makes us curious of the relationship of
those two terms. Why do light and truth go together?
2 There are events in the old scriptures and also in the new scriptures that describe
visions of celestial beings (angels or messengers) to the prophets. In every occasion, the
celestial being is described as being surrounded by a light "more brilliant than the
sun". What kind of light could be to be more brilliant than that of the sun?
3 Just like Christians are instructed to pray and communicate with God. The scriptures are
full of descriptions in which people communicated with God by prayer and most important
they have received answers. Since the distance in space is without borders the curiosity
arises regarding what way messages travel.
eft">
We will discuss the truth or facts first. We have to consider the difference between the
truth (or fact) and the theory of the scientists. The theory is a good attempt to explain
several observations. A Theory becomes accepted as fact, or law of nature, if it is able
to overcome all the required tests under every condition
The most important scientific facts remain in the category of theories, because the
scientists are not able to prove with surety or with pure facts. The true base of the
scientific progress is based on sure proofs that they should come after a continue
research.
In the last days, men will be like this scripture explains:
7 Ever learning, and never able to come to the knowledge of the
truth. 2 Timothy 3:7
The religious declarations presented in the scriptures should be
accepted like truth (or facts) if they are translated and presented
like God intended it to be done. The final test will remain an individual testimony
by the Holy Ghost.
1 Corinthians 2:14-15
But the natural man receiveth not the things of the Spirit of God:
for they are foolishness unto him: neither can he know [them], because
they are spiritually discerned.
But he that is spiritual judgeth all things, yet he himself is
judged of no man.
The scientific information gives rationality to the mind.
The whole truth, without regard of the source, gives peace to the soul.
Let's enlarge our thought about the truth in a different discussion.
Let's consider a theory that "The truth is a sharp connection between
the spiritual and the physical" We will discuss this theory later.
Means that improve our senses.
The natural man learns by his senses. These senses are limited,
so sometimes we use means to try to improve them. Using them, it is
possible to enlarge our knowledge. Using certain devices, we can hear sounds otherwise
unheard. We can see the smallest things otherwise
invisible, with microscopes or telescopes.
We can see trough the universe things impossible to see by our natural
eyes. This list could be very long. With these devices, the scientists can explain
theories that bring us closer to truth and so on.
The Urim and Thummim:
At the very beginning of the religious story, we find that Moses
described a device that was used to enlarge the spiritual senses of
the man. This device is described in Exodus 28 and it is called the Urim
and Thummim it means "light and truth"
Aaron used it in the hard judgment of the sons of Israel
before the Lord. This helped him to know the truth, regarding the sons
of Israel. Moses then consecrated Aaron and gave him the rod and the Urim
and Thummim. Mosiah 28:13-16
13 and now, he translated them by the means of those two stones, which were fastened into
the two rims of a bow.
14. Now these things were prepared from the beginning, and were handed
down from generation to generation, for the purpose of interpreting
languages;
15 And they have been kept and preserved by the hand of the Lord,
that he should discover to every creature who should possess the land
the iniquities and abominations of his people;
16 And whosoever has these things is called seer, after the manner of
old times.
Mosiah translated the records by the Urim and Thummim. This device was
similar to the one described by Moses. In our times, Joseph Smith was given the same
device to allow him to translate the Book of Mormon and the Pearl of Great Price.
This device gave to him an ability that was otherwise impossible.
Abraham 3:1-4
1 AND I, Abraham, had the Urim and Thummim, which the Lord my God had
given unto me, in Ur of the Chaldees;
2 And I saw the stars, that they were very great, and that one of
them was nearest unto the throne of God; and there were many great
ones which were near unto it;
3 And the Lord said unto me: These are the governing ones; and the
name of the great one is Kolob, because it is near unto me, for I am
the Lord thy God: I have set this one to govern all those which belong
to the same order as that upon which thou standest.
4 And the Lord said unto me, by the Urim and Thummim, that Kolob was
after the manner of the Lord, according to its times and seasons in
the revolutions thereof; that one revolution was a day unto the Lord,
after his manner of reckoning, it being one thousand years according
to the time appointed unto that whereon thou standest. This is the
reckoning of the Lord's time, according to the reckoning of Kolob.
Abraham could study the universe a lot better then the Palomar's
telescope, using the Urim and Thummim.
Observation.
a) The knowledge of the man is limited, but the eternal truths are not
limited only to man.
b) We have to find the truth where it can be found, whether from religion or from science.
c) Theology should include the sciences, like a method of
explanation and observation of the creations or the laws of God.
d) For scientists to exclude religion for possible angles of
truth it is not scientific.
e) We as LDS members were warned to search the scriptures for truth and answers to our
problems, rather than go on partial truth, and in many instances, false theories developed
by men and especially
non-religious men.
LIGHT AND SCIENCE
Example of man "always learning"
James Maxwell taught that the light is bent by electromagnetic
forces.
Isaac Newton taught that the light is corpuscle. "The sun and all the
other light bodies have the property to send little particles of
their substance to an unbelievable speed and these particles going in
the our eyes give us the feeling of vision."
Louis De Broglic (1946) put all of this together and declared that the
light was not something touchable; it means that the
energy is so tiny that it cannot be used, only to light. The coming up
of the laser and other devices has proved with surety that the light
can be touchable.
Science now accepts that light is a form of matter, a form of wave, which contains
particles.
Science said, for a long time, that all the energy of the earth
comes from the sun in the form of light waves. The sun sends
approximately 50 billion calories of light per second. With this
emission it is easy to believe that the sun in few billions years
will be consumed. Fred Hoyce (scientist of Cambribge) doesnt agree
regarding this.
"The waves of light from the sun arrive on the earth in a variety of
short waves, like gamma rays, x-rays etc. Matter, above or
inside the earth absorbs a certain quantity of this energetic light,
transforming it into warm energy, using some of it for a later use (gas
and coal) and at the end, these rays go back in the space as long
waives. All the earthly matter is sent back in part, proportional to the
fourth part of its absolute temperature, therefore the earth,
including the people, are sending back particles. We don't have a
measure for the short waves, but when those become long waves we know
how we can measure them. The atmosphere is warmed by the long waves
that are coming back from the earth, not from the short waves that are
coming in.
Another example of men "always learning"
Dr. Dalton taught that the atom was the base to build a block
of matter. He produced the atomic base that we use today and we update
it with the new elements that are discovered. The name "Atom" was used
because it means "indivisible". It was accepted like a law of nature
that the atom was the smallest unit that it could exist. This was
until we discovered inside of it, electrons and protons and
neutrons. At the beginning of 1972, the University of Stanford
claimed the division of the electron in their laboratory. Since the
particles of light are considered to be a form of matter, it will be
interesting to see how long we will need to divide the particles that
come from the division of the electron, possibly from the division of
those and at last, to arrive to particles of light.
It could be that the science in the future will be able to identify light like it was the
base to build matter? There are theories formulated, but at this moment the science it is
not sure.
LIGHT AND RELIGION
Most of us, in the past, using the word "Light" used like a religious
term, probably intended to mean "Clarity and comprehension". In the
expressions: I see the light, means, "I understand". Probably
there were not enough reasons to consider the word "Light" in the religious
sense, like it had some relationship to physical light, defined
by the sciences. Surely the scientist didn't put in relationship the
ideological meaning of light like it had some old association with the
physical light. Like we search the scriptures, we find that the Lord
revealed to Joseph Smith that there is a connection between the
physical light, like defined by the science, e clarity like used from
the religion.
D&C 88:11-12
11 And the light which shineth, which giveth you light, is through
him who enlighteneth your eyes, which is the same light that
quickeneth your understandings;
12 Which light proceedeth forth from the presence of God to fill the
immensity of space--
Light and matter- Religion.
Moses and Abraham told us in the scriptures that God organized the
earth spiritually and after He made it mortal. From this is possible
to say that the man and all the other creations have 2 identity, We
teach that the man has a mortal body coexistent in some way with a
spiritual body. The combination is a "Living soul"
In the past we didn't really considered the kind of matter used by God
to organized the spirit of the man, but we went to a great distance to
analyze the matter used to organize the mortal body. The Lord revealed
to Joseph Smith in D&A 131:7
7 There is no such thing as immaterial matter. All spirit is matter,
but it is more fine or pure, and can only be discerned by purer eyes;
Here we are told that the spiritual bodies are blocks of matter. D&A
88:12-13
Which light proceedeth forth from the presence of God to fill the
immensity of space--
D&C 88:13
13 The light which is in all things, which giveth life to all things,
which is the law by which all things are governed, even the power of
God who sitteth upon his throne, who is in the bosom of eternity, who
is in the midst of all things.
Double nature of the Light
The science has for a long time researched the double nature of the
light, like a wave of particles. A theory suggests that putting
together a group of waves in a sufficient quantity we can form a mass
of matter.
Another theory that it is studied right now suggests that a stable
waves could be an axe orbiting of whose particles of light could be
connected and orbiting and become a mass of matter.
The scientist Carenkov received the Nobel for his theory and verify of
the light. His theory, that was proven in laboratory, identified a
double nature of the light like a " group of particles, which they
were bended and Phase particles, which were tiny particles prolonged
from the group of particles. Aging in a particular manner on the
light, he was able to divide those particles phase from the principle
body of the particles. This is called the Canrenkov's radiation. It is
possible that the science is close to identify the spirit, or tiniest
matter but not knowing really what they are observing they don't
understand the reality.
The our first question at the beginning was: How light and truth are
connected?"
We are told in the scriptures that we were alive like intelligence,
before we were organized in spiritual bodies. We accept this even
though, in our present estate of mortality, we can totally understand
this, because in some way now we are missing the capacity to
comprehend the eternity.
D&C 93:29-30
Man was also in the beginning with God. Intelligence, or the light of
truth, was not created or made, neither indeed can be.
D&C 93:30
30 All truth is independent in that sphere in which God has placed
it, to act for itself, as all intelligence also; otherwise there is no
existence.
D&A 84:45-46
45 for the word of the Lord is truth, and whatsoever is truth is
light, and whatsoever is light is Spirit, even the Spirit of Jesus
Christ.
46 And the Spirit giveth light to every man that cometh into the
world; and the Spirit enlighteneth every man through the world, that
hearkeneth to the voice of the Spirit.
Truth and light go together. In fact, the truth is a particular form
of light, coming from God, trough Christ to every man that is coming
to this world. I suggest that you could consider a theory that" The
truth is a sharp connection between the spiritual and the physical. We
could say that you, living soul, are a spiritual and carnal body, matter composes you and
this matter is light, which is the base of
the building. The kind of light used is named "Truth", in this case
every fiber of your being is from God and could be controlled by Him,
trough Jesus, if you want to listen to Him. This light is a gift, if
you want that the light be in control you have to accept the laws
that are in control of that (commandments)
The Kirlian's Photography
Professor Douglas Dean of Newark, spake regarding important scientific
experiments. He observed by help of devices like computers, lasers and
other devices like these, the waves of the human brain could be
measured and photographed. These devices could listen and recorded
thought waves of a person far away about 200 meters.
The scientist Semyon Kirlian showed the pictures of the waves of light
coming from our body. Several of his pictures were showed in TV in USA
during the February of 1973. The pictures showed the white light that
was coming from the fingers, after that the person drunk alcoholics,
the white light became red. Different colors were coming from
different parts of the body, and those techniques are starting to be
used to developed medical analyses of the function of the body,
observing the change of the colors. A strange and important
observation was done regarding a leave cut a half. The picture was
showing that the part cut was present in the picture in the form of
white light.
Even a man armless was photographed and the pictures showed a light at
the place of the arm missing. The professor called this light "a
special energy done from a living spirit or bioplasma. Once again, is
it possible that the scientists are identifying the spiritual body and
the carnal body like a double entity and still they don't know really
what they are seeing? Is it possible that the carnal arm of the man
could be cut and still the same spirit arm cannot be cut?
This is the story of Semyon Kirlian. In the 1939 he touched
accidentally an electrode, he received a little electricity and he
saw something like a little lightening. Kirlian was just curios to
see what would be happen if in between there has been photography.
He tried several times and the result was always the same, He could
see that his body was sending radiations in a form of light and this
light was around the whole body. Fascinated from his discovery he
built a device able to make pictures at high tension. He made a
special visor that was able to show directly the effects like on TV.
After his discovery begun many discussions. Several scientists maintain
that the brightness showed from the pictures is "our spirits",
several others refuse this theory but they don't have any other
explanation. Well at least we could say that Semyon Kirlian has opened
a fascinating field of exploration. This field anyway it is not
completely new. In the 1890 a scientist, Nikola Tesla, made several
tests in the United States, very similar to the Kirlian's experiment,
the researcher George de la Warr, in the thirties, discovered the
existence of weak field of force electromagnetical around the body, He
was able to show that this entity would have been different according
to the health and the humor of the person. Anyway today this is
called Kirlian photography because he was the real first to put
scientific bases on this particular kind of photography. Once it
happened something very interesting, other scientist came to visit him
and strangely his device seemed to be broken are at least no working,
he was trying to take a picture of his fingers, but nothing happened,
after a while he fainted and was brought to bed. His wife Valentine
went back to the device trying to show to the scientists how it worked
and strangely this time the device was working perfectly. Anyway this
fact important because Kirlian when got better went back to the device
and he noticed that the light coming from his hand was better but not perfect like the
other times, but surely better than a few hour before when nothing was happening. So in
this way he understood that the
device was not able to receive any light from his body because his
body was seek. He wrote:" In the human beings is possible to see if
they are in good health or not seeing the radiation they are sending.
We have created this device to write this analyzes now we need another
to decode his results.
After that they did the experiment of the leave and the man armless like
quoted before. Naturally Semyon and Valentina never declared to
believe in the existence of the spiritual body, but on the other side
they don't have any valid explanation for that.
Like I said every person send radiations, is it possible that our
thoughts could be transmitted in the space where they can be received
from greater intelligences?
Is it possible that the welfare of our bodies could be observed with
purer eyes?
Communication.
Like we quoted before, the scientist Karenkov identified the double
nature of the light like it was a group of particles that are going to
the speedy of the light (186000 at second). Putting the light in
particular conditions he find that the phase particles improve the
speedy at the double of the group of particles, or approximately at
34,6 billions of miles at second. Most of the other scientist maintain
that this waived particles are non understandable. This is a familiar
declaration, since several terms were applied to the light from the
scientist in 1946. To the speedy of 34,6 billions of miles for second,
this particles can go to the sun and come back 19 times in a second.
Is it possible that your spiritual mind can send thoughts or messages
to the speedy of the light?
Is it possible hat spiritual beings, appearing in glory,
brightening like the sun, are traveling and communicating to a speedy
so far, not understandable for us or bigger than the speedy of the
light?
Since God control all the light and since we are done of light and
since our thoughts create radiations of lights, is it possible that
God with his intelligence (or glory) can gather and organize the
light to form worlds and living things, simply thinking about that?
Could he change our earth and us too in just a moment?
It is written that the carnal man can't see God and live. This is
true, but anyway God can change the carnal eyes or something else in a
way that the man can see him and other celestial beings, there are so
many scriptures able to prove this concept. The scriptures talk about
this process like "quickening", according to me quickening means a
greater speedy in the dimension of the time. Then the spiritual eyes
of the carnal man could see the spiritual body of the celestial
visitor.
Moses 6:61
61 Therefore it is given to abide in you; the record of heaven; the
Comforter; the peaceable things of immortal glory; the truth of all
things; that which quickeneth all things, which maketh alive all
things; that which knoweth all things, and hath all power according to
wisdom, mercy, truth, justice, and judgment.
D&A 88:49-50
9 the light shineth in darkness, and the darkness comprehendeth it
not; nevertheless, the day shall come when you shall comprehend even
God, being quickened in him and by him.
50 Then shall ye know that ye have seen me, that I am, and that I am
the true light that is in you, and that you are in me; otherwise ye
could not abound.
The creation theory,
like mentioned before, the earth receive its energy from the sun and
that generally the scientists think that the sun will be over in
several millions of years. Exception to this theory was given from
Fred Hoyle of Cambridge, England; in his book "Some recent research
about the sun"
Mr. Hoyle describes his theory. This theory specifies that our sun
shouldn't finish and that it is receiving more energy from other
sources. This theory is consistent with what was showed to Abraham
4000 years ago, by the Urim and Thummim. Abraham says that the first
help of energy comes from the celestial kingdom by Kolob and it goes
even to our sun. For a long time the scientist considered 12 Galaxies
(including our Milk Way) like they were a local group. Fred
Hoyle in his sample spatial identifies 13 galaxies like group.
Recently the Dr. Sharley with the help of radio telescopes has counted
20 galaxies. Thus the present science is not sure about the real
number of galaxies of our group, ma could be a total of 16. Our
scientists have the theory that from other part exists an universal
center of control of many galaxies and that every family of galaxies,
like our present group has a possible center of control of several
suns and celestial bodies and that our sun controls our system. Always
the scientists don't accept generally that this solar system of
control is associated with sending solar energy. The theory of Mr.
Hoyle accepts is sending solar energy to our sun from another
source or another galaxy to control. Abraham was shown that
Kolob was the closest residence to God and that it was a great key or
center of control of other worlds, like Oliblish and Kae van rash,
even Kae van Rash was the center of control of other 15 galaxies.
Abraham says that this earth receives energy from the sun; the sun
receives the energy of Kae Van Rash, which is receiving the energy
from Kolob. Abraham says that Kae Van Rash controls 15 more galaxies
beyond ours, therefore 16 galaxies. If Doctor Shapely could read
Abraham, probably he could remove his doubts regarding the 4 galaxies
in difference and would be in harmony with the total of 16 galaxies of
our group.
A Facsimile from the Book of Abraham
No. 2
Picture 5 is called in Egyptian "Enish go on dosh" is even one of the
governing planets, that the Egyptians maintain to be the sun, which is
receiving its light from Kolob through Kae Van Rash, which
is the great jey, or, in other terms the governing power, which govern the
other 15 planets, or stars. Like Floese or the moon, the
earth and the sun, in their revolution yearly. This planet receives its
power through Kli flos is as or Hah KO Kan beam. The stars represented
by the numbers 22 and 23, which receive their light from the
revolution of Kolob.
In speaking of the radiation of Karenkov and the high speed of
the phase particles, their problem is obvious. How it is possible for
our prayers (or thoughts) to arrive to God (that apparently is near to
the center of our universe) and that his answers come to us instantly?
Even at 186,000 miles per second, this would seem to take a
lot of time for to travel there and come back. Science and scriptures
suggest a possible solution for this paradox.
(We discuss this further in a later talk dealing with time)
Scientific studies and relativity, like described from Professor
Albert Einstein
Einstein accepted the proofs of laboratory and the observations of
Lorenz Fitzgerald. Those proofs showed how the speedy particles become
shorted in the direction of the movement, whether in the time or in space, like the
particle is going to be near to the speed of light (186,000 miles per second) its length
becomes short and its time
become less and so on until you arrive to zero, like space and
time.
This means that a person can leave this planet and travel in space toward a planet far
away 1000 times the speed of light. The traveler would have done the trip so fast that he
wouldnt have been gone. The time of his travel would have gone to zero.
Time zero (Time is always present, the time of God)
it is hard for us to understand zero time, also it would be very
confusing for us to live in the eternity (or eternal state) without time. Abraham
understood zero time, or the theory of relativity.
Explanation of the picture above fig 1,
Kolob, signifying the first creation, is nearest to the Celestial, or the
residence of God. Kolob is first in government, the last pertaining to the
measurement of time. The measurement according to celestial time,
which celestial time signifies one day to a cubit. One day in Kolob
is equal to a thousand years according to the measurement of this
earth, which is called by the Egyptians Jah-oh-eh.
In celestial time we would compare a day (1000 years of our time or 1
revolution of Kolob) to a cubit. A cubit is 18 inches. Here Abraham
erased the time and put at its place a short line of 18 inches, though in
the celestial kingdom we won't be conscious of the time, but we will
substitute it with a revolution of Kolob.
The scriptures in fact do speak about the zero or present time
D&C 88:110
And so on, until the seventh angel shall sound his trump; and he shall stand forth upon
the land and upon the sea, and swear in the name of him who sitteth upon the throne, that
there shall be time no
longer;
D&A 84:100
The Lord hath redeemed his people; And Satan is bound and time is no longer.
Revelation 10:5-6
And the angel which I saw stand upon the sea and upon the earth
lifted up his hand to heaven,
And swear by him that liveth for ever and ever, who created heaven,
and the things that therein are, and the earth, and the things that
therein are, and the sea, and the things which are therein, that there
should be time no longer:
Alma 40:88 Now whether there is more than one time appointed for men to rise, it
mattereth not; for all do not die at once, and this mattereth not; all
is as one day with God, and time only is measured unto men.
Science has accepted that the time is in the space a 4th dimension
and it is variable.
On 8/11/1972 the United States government sent an airplane
with 2 atomic watches, they were synchronized with two other watches on the
earth. Those watches were so accurate that could make a mistake of
billionths of a second in a year. The airplanes flight was above the earth
from the North Pole to the equator. The results were explained from a
computer that said the watches on the flight were going slower than
the others on the earth. So in this case there is nothing impossible for God because space
and
time is for him his own environment.
When a ray of light touches a body, if it happens to be the frequency of
the light it is in sync with the matter which
When a ray of light touches a body, if the frequency of the light is in harmony with
the matter that is striking, the light is all absorbed from the matter.
D&C 88:67
We should live to sanctify our bodies, spiritual and carnal, to be in connection with the
glory in which we desire to be in the eternity.
D&C 88:21-24
Light and Darkness
It is my idea that the lord is referring to the different glories of his kingdom when he
is referring to a different areas of intelligences or light of truth, therefore he is
saying that in the houses of glory there is a different level of power and glory.
D&C 88:37-40
If our bodies are not in harmony with the fixed glory we can't abide it. We will not be
able to abde the light of glories that are above our ability to endure. Isaiah saw the
power of the celestial kingdom: "Who could abide to the devouring fire? Who could
resist to the eternal fire? The man walking by the path of righteousness and who speak of
justice."
Our Goal
If you desire to live and abide a celestial glory, you should live it now and learn to
live the laws that will allow us to be in harmony with the celestial glory.
THIS EARTH WILL BECOME A CELESTIAL GLORY.
D&C 130:9-10
Our thoughts go to heaven and are recorded. Our actions are visible to those who possess
an Urim and Thummim (or stone). This is the time to sanctify ourselves and to think in
harmony with the will of God.
Only in the scriptures and doctrines of the Church of Jesus Christ LDS we can find the
laws that rule the Celestial Kingdom.
D&C 93:27-28
D&C 93:33-38
To go back to The Bible and the Book of Mormon